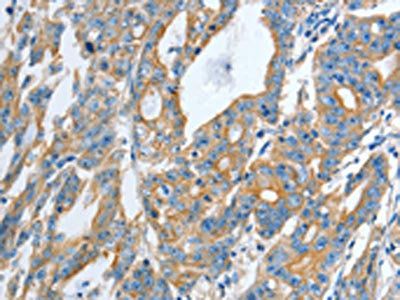
TNFSF13 Antibody

You have no items in your shopping cart.
Human APRIL protein
SKU: orb1216296
Description
Images & Validation
−
Key Properties
−| Source | Yeast |
|---|---|
| Biological Origin | Human |
| Target | APRIL |
| Molecular Weight | 16.4 kDa |
| Protein Length | 146.0 |
| Protein Sequence | AVLTQKQKKQ HSVLHLVPIN ATSKDDSDVT EVMWQPALRR GRGLQAQGYG VRIQDAGVYL LYSQVLFQDV TFTMGQVVSR EGQGRQETLF RCIRSMPSHP DRAYNSCYSA GVFHLHQGDI LSVIIPRARA KLNLSPHGTF LGFVKL (146) |
| Purity | 98% |
Storage & Handling
−| Storage | -20°C |
|---|---|
| Form/Appearance | Lyophilized |
| Disclaimer | For research use only |
Alternative Names
−TNFSF13
Similar Products
−
Quality Guarantee
Explore bioreagents carefree to elevate your research. All our products are rigorously tested for performance. If a product does not perform as described on its datasheet, our scientific support team will provide expert troubleshooting, a prompt replacement, or a refund. For full details, please see our Terms & Conditions and Buying Guide. Contact us at support@biorbyt.com.
Quick Database Links
Gene Symbol
APRIL
Documents Download
Datasheet
Product Information
Request a Document
Protocol Information
Human APRIL protein (orb1216296)
Based on 0 reviews
Participating in our Biorbyt product reviews program enables you to support fellow scientists by sharing your firsthand experience with our products.
Login to Submit a Review